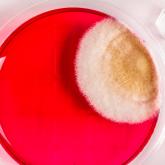
Петритест

Петритест
О компании
НПО "Альтернатива" - производитель пищевых ингредиентов, комплексных пищевых добавок, микробиологических экспресс-тестов.
Микробиологические экспресс-тесты Петритест - это готовый тест для микробиологического анализа сырья, полуфабрикатов, готовых продуктов питания и окружающей среды. По своему функционалу, стоимости и удобству применения Петритест заметно выделяется среди известных зарубежных производителей.
Экономьте ресурсы и получайте самый лучший результат вместе с Петритест.
Петритест - это российский аналог таких тест-систем, как
Дипслайд, Petrifilm, RIDA COUNT, Oxoid, Orion Diagnostica, Schülke & Mayr, Merck Millipore, Singlepath, Duopath, MVP ICON, HY-RiSE, Envirocheck Dip Slides, MC-Media Pads , Sampler, HYCON Contact SlidesQuant
Контакты
Реквизиты
Расположение на карте

Основной деятельностью ПКФ "ИЗОЛИТ-ДЕТАЛЬ" является поставка и производство электроизоляционных материалов и деталей из них.
Саратоворгсинтез - ведущий производитель нитрила акриловой кислоты, ацетонитрила и цианида натрия в России.

Наша компания является производителем каучуков, сырых резиновых смесей, резинотехнических изделий.

Компания «ИМТК» работает на российском рынке с 2002 года, предлагая потребителям ленту упаковочную полипропиленовую (стреп-ленту) собственного производства.

“Полипропилен – Сервис” производит нить полипропиленовую и шпагат.
- Телефон: +79033...
- Почта: petri...
- Сайт: https://petritest.ru/